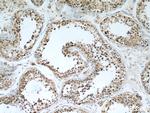
FAF2 Antibody in Immunohistochemistry (Paraffin) (IHC (P))

Search
Proteintech
FAF2 Polyclonal Antibody
{{$productOrderCtrl.translations['antibody.pdp.commerceCard.promotion.promotions']}}
{{$productOrderCtrl.translations['antibody.pdp.commerceCard.promotion.viewpromo']}}
{{$productOrderCtrl.translations['antibody.pdp.commerceCard.promotion.promocode']}}: {{promo.promoCode}} {{promo.promoTitle}} {{promo.promoDescription}}. {{$productOrderCtrl.translations['antibody.pdp.commerceCard.promotion.learnmore']}}
产品信息
16251-1-AP
种属反应
已发表种属
宿主/亚型
分类
类型
抗原
偶联物
形式
浓度
规格
纯化类型
保存液
内含物
保存条件
运输条件
产品详细信息
Immunogen sequence: YLIMLPFRF TYYTILDIFR FALRFIRPDP RSRVTDPVGD IVSFMHSFEE KYGRAHPVFY QGTYSQALND AKRELRFLLV YLHGDDHQDS DEFCRNTLCA PEVISLINTR MLFWACSTNK PEGYRVSQAL RENTYPFLAM IMLKDRRMTV VGRLEGLIQP DDLINQLTFI MDANQTYLVS ERLEREERNQ TQVLRQQQDE AYLASLRADQ EKERKKREER ERKRRKEEEV QQQKLAEERR RQNLQEEKER KLECLPPEPS PDDPESVKII FKLPNDSRVE RRFHFSQSLT VIHDFLFSLK ESPEKFQIEA NFPRRVLPCI PSEEWPNPPT LQEAGLSHTE VLFVQDLTDE (97-445 aa encoded by BC014001)
靶标信息
The protein encoded by this gene is highly expressed in peripheral blood of patients with atopic dermatitis (AD), compared to normal individuals. It may play a role in regulating the resistance to apoptosis that is observed in T cells and eosinophils of AD patients.
仅用于科研。不用于诊断过程。未经明确授权不得转售。
生物信息学
蛋白别名: expressed in T-cells and eosinophils in atopic dermatitis; FAS-associated factor 2; protein expressed in T-cells and eosinophils in atopic dermatitis; UBX domain containing 8; UBX domain protein 3B; UBX domain-containing protein 3B; UBX domain-containing protein 8; unnamed protein product
基因别名: 2210404D11Rik; AI462440; ETEA; FAF2; KIAA0887; mKIAA0887; RGD1306577; UBXD8; UBXN3B
UniProt ID: (Human) Q96CS3, (Rat) Q5BK32, (Mouse) Q3TDN2
Entrez Gene ID: (Human) 23197, (Rat) 291000, (Mouse) 76577